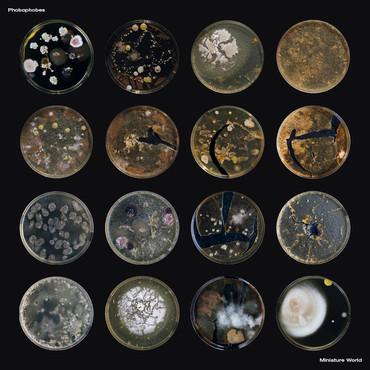
Phobophobes - Miniature World, Cd's en Dvd's, Vinyl | Pop, Gebruikt, Verzenden

Kenmerken
Conditie
Gebruikt
Beschrijving
Format: LP, Album, Ltd, Cle
Media Condition: Mint (M)
Sleeve Condition: Mint (M)
Sealed! New product!
Label: Ra-Ra Rok Records
Country: UK
Released: 2018
Genre: Rock
Style: Alternative Rock, Indie Rock
Tracklist:
A1. Where Is My Owner
A2. Miniature World
A3. Human Baby
A4. The Never Never
A5. Free The Naked Rambler
B1. Child Star
B2. No Flavour
B3. The Fun
B4. Mama Power
B5. Bite The Apple
...
...
...
...
...
...
...
...
...
...
...
...
Teuven
0x bekeken
0x bewaard
Sinds 26 jan '26
Zoekertjesnummer: a158905026
Populaire zoektermen
gratis vinyltaylor swift vinylpartij vinylabba gold vinylvinyl billie eilishvinyl collectievinyl coldplayopbergbox vinylgeorge michael vinylmadonna vinyldepeche mode vinylmadness vinyl lpvinyl nana mouskourigratis vinylbubbelbad in Bubbelbaden en Hottubstypemachine mercedes in Antiek | Kantoor en Zakelijkkoers wielen in Fietsen | Racefietsenmarklin 3016 in Modeltreinen | H0z-drive in Motorboten en Motorjachten255 30 20 banden in Banden en Velgene46 in Modelauto's | 1:18denon in Versterkers en Ontvangersmetaal in Naaimachines en Toebehorentopkoffer sym in Scooters | SYM